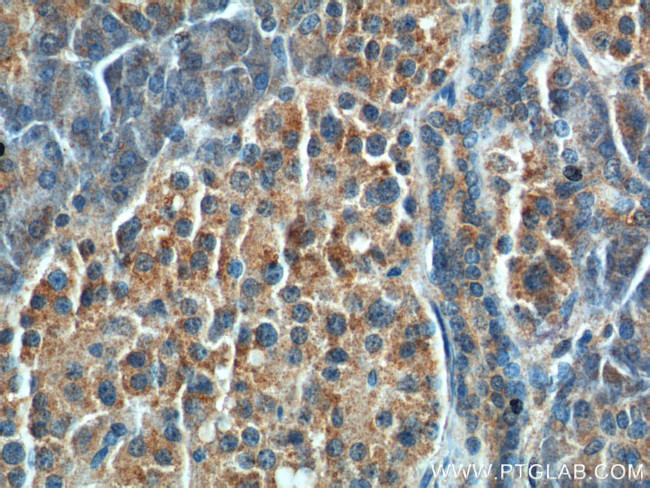
CCK Antibody in Immunohistochemistry (Paraffin) (IHC (P))

Search
Proteintech
CCK Polyclonal Antibody
{{$productOrderCtrl.translations['antibody.pdp.commerceCard.promotion.promotions']}}
{{$productOrderCtrl.translations['antibody.pdp.commerceCard.promotion.viewpromo']}}
{{$productOrderCtrl.translations['antibody.pdp.commerceCard.promotion.promocode']}}: {{promo.promoCode}} {{promo.promoTitle}} {{promo.promoDescription}}. {{$productOrderCtrl.translations['antibody.pdp.commerceCard.promotion.learnmore']}}
产品信息
13074-2-AP
种属反应
宿主/亚型
分类
类型
抗原
偶联物
形式
浓度
规格
纯化类型
保存液
内含物
保存条件
运输条件
产品详细信息
Immunogen sequence: MNSGVCLCV LMAVLAAGAL TQPVPPADPA GSGLQRAEEA PRRQLRVSQR TDGESRAHLG ALLARYIQQA RKAPSGRMSI VKNLQNLDPS HRISDRDYMG WMDFGRRSAE EYEYPS (1-115 aa encoded by B C008283)
靶标信息
Cholecystokinin (CCK) is a neuropeptide hormone and neurotransmitter widely distributed throughout the gastrointestinal (GI) tract and the central nervous system (CNS). Antibodies that react specifically with CCK are useful for the study of the mode of action, differential tissue expression and intracellular and subcellular localization of CCK in the CNS and periphery as well as in neuroendocrine cells of the digestive system.
仅用于科研。不用于诊断过程。未经明确授权不得转售。
生物信息学
蛋白别名: CCK; Cholecystokinin; cholecystokinin octapeptide; cholecystokinin triacontatriapeptide; prepro-cholecystokinin; unnamed protein product
基因别名: CCK
UniProt ID: (Human) P06307
Entrez Gene ID: (Human) 885